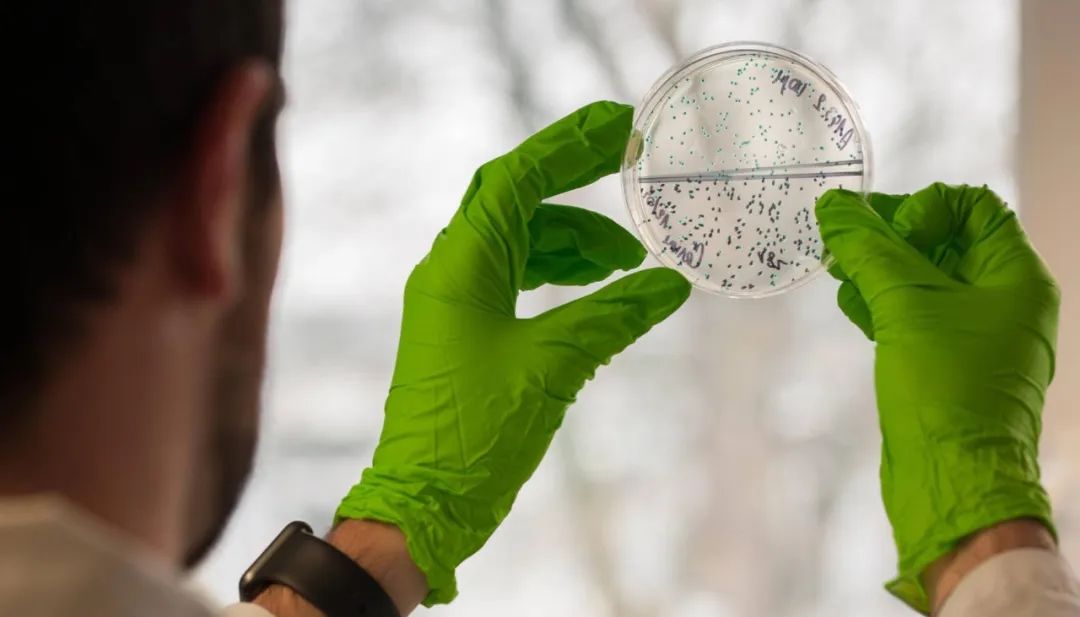
耶鲁mit学霸,被斯坦福录取的高中生

对于课外活动
你是不是还停留在:
矜矜业业写BP后在创业大赛拿个好名次
艺术团内踊跃表现再参与各大钢琴演出
和小伙伴在实验室内操作酒精灯、试管......

然而有的留学*党**到了申校季节
朋友圈却展示完全不同的一个“新天地”:
在追Nike最新发布的潮鞋,天天刷INS/FB
PO出国内各种风景美照,仿佛在游山玩水
甚至在晒炒股曲线图,今天股票又涨了
令人不禁疑惑
难道他们都不着急吗?
更疑惑的是
最后他们都晒出来TOP 30名校的Offer!

重点来了
不是他们只是在玩、游手好闲
而是在于真正选择了合适的课外活动!
在追逐梦想的道路中,最重要的是
找准自己的方向,让效率、效果最大化
疫情期间更是你赶上学霸的“黄金时期”
线上+线下结合
疫情期间参加全球顶级教授线上科研项目
暑假期间直接在实地进行高质量课外活动
10天时间、顶尖名师配置、offer命中率高
给自己选一个逆风飞翔的方向吧!
✓你将直接踏进藤校实验室大门
✓你能参与名校真实的学科活动
✓直接加入TOP30名校活动团队
✓亲手完成一份高规格活动成果
✓获取名校教授的诚挚推荐信
考虑到疫情问题
无论线上或线下
马上选择一个尖端活动
名校offer、自我提升两不误
【2020年】
沃顿、中科院
13种课外活动
商科、理工科、社科人文
三大方向供你选择
【适合你的,才是最好】
这些课外活动能保证你有4个收获:
1. 一个由活动、推荐信、作品支持的背景提升;
2. 一套帮助你实现目标的能力构建系统;
3. 帮你找到和名校教授认识的交流机会;
4. 发表国际高端学术期刊的机会
☆☆☆☆☆
让老外别只会来中国学功夫
国家非遗文化与技艺传承志愿者项目

心动 指数: 9分
适合方向: 人文、设计、工艺、美术、商科
项目地点: 北京·故宫
打开淘宝、小红书、抖音,漫天遍地都是同质化的审美:简约北欧风、小清新INS风、法式浪漫风……所有事物似乎都是一个模板印刷而出,毫无创意。
在全民审美越来越同质化的今天,提高审美、品味,挖掘个人特质才是你脱颖而出的重点。
不用去巴黎、欧洲,5000年的中华文化,就是你最好的艺术、商业灵感源泉。
来故宫,一次史上最强“网红”打卡之旅,就是提高审美的绝佳机会。
这一次,你将认真从故宫的艺术文化出发,以网红角度,结合商业去打造“中华文化”:
——学习运营IP,和文创界的大咖们一起学习品牌营销
——探讨品牌营销,为你未来的艺术品牌铺下基石
——进行内容制作学习,巧妙把握创新X非遗的平衡
除此以外,你将观赏这个全球最大的博物馆的藏品,进一步提高你对中华艺术的审美和理解。亲自动手——也是你这次旅程的重点,你会在国家级工匠的指导下亲手制作金属画,在手中制作第一件艺术品,看到传统文化如何在你的手中焕发生命。
网红不用摆拍,故宫用5000年的文化告诉你,这才叫“中国网红”。
此项目学生人均获得Offer数: 6.53份

特别收获:
-
非遗技艺传承人导师亲笔签发的推荐信
-
国家非遗文化与技艺传承志愿者项目证书
了解更多非遗技艺项目信息
错过这次,只能再等一年
提前退休?用数字赚出10年收入
沃顿商学院股票交易金融训练

心动 指数: 9分
适合方向: 金融、创业、商科
项目地点: 线上授课
对于最新中产阶级标准是个人财富达到100W,这时候,你才能说可以“退休了”。
而要实现这个目标,大部分需要的时间是10年以上。
然而世界上总有些人 ,10天便有机会达到别人需要10年才能实现的梦。
快速积累财富,不是靠垃圾广告里面“月入10W不是梦”,而是——理财投资。无论你出身于哪种家庭,掌握金融知识,大到一夜暴富,身价暴涨;小到买买基金,实现每年10%个人增值,都会让你受益终身。
前提是,你要有 扎实的金融知识和专业的投资训练,这才是培养出你在投资市场中的“手感”。
在本次项目中,沃顿顶尖教授会手把手带你玩投资,深入了解各种金融衍生品和股票交易技术,提升你的投资策略思维,从K线图中看懂股票走势,培养出你快狠准的眼光,让你秒杀其他玩家。
他会告诉你,看懂K线图不算什么,用K线图赚100万才牛逼。
此项目学生人均获得Offer数: 6.85份
特别收获:
-
全球TOP10学校终身教授推荐信
-
国际期刊专业论文发表
了解更多金融研究项目
错过这次,只能再等一年
学会像CEO般思考
麻省理工斯隆商学院市场营销班

心动指数:9分
适合方向: 创业、商科
项目地点: 线上授课
漫威在濒临破产边缘通过《钢铁侠》起死回生;星巴克在全球推行“地理即风味”的咖啡品尝方式大获成功……
对于企业家而言,最重要的便是如何把合适的商品卖给合适的人。
就算只是仅仅几个字的Slogan,背后也是经过无数权衡和博弈,最后得出的结果。
因为这背后,正是市场营销的魔力,有时候甚至能决定一家公司的生死。
如果你的未来计划是成为企业家、公司创始人、500强企业职业经理人:
别犹豫,跟随MIT教授,做出你第一个商业雏形计划。
这个项目中,各种营销玩法从此开始填补你空白的大脑,你甚至会慢慢理解,一家公司的兴衰成败,一场营销背后的水深水浅。
18岁了,送给自己最好的成年礼:开始就是像个CEO般思考。
此项目学生人均获得Offer数: 5.85份
特别收获:
-
全球TOP10学校终身教授推荐信
-
国际期刊专业论文发表
了解更多项目内容
让招生官成为你的粉丝
潮牌与体育品牌的融合创新研究

心 动指数: 9分
适合方向: 市场营销、商科
项目地点 : 北京
Yeezy椰子鞋,相信没有一个玩潮牌的人会不知道。但是很少人知道的是,Kanye West的这个公司预计今年估值将突破 10亿美元。
陈冠希、侃爷、Travis Scott……在Instergram上的生活都是豪车、豪宅,过着2000粉丝羡慕的生活。
如果有一个机会,把你的爱好和职业完美结合,那个机会就是:打造你的个人品牌 。
从国内到国外,只要是红遍全球的潮牌,都有丰富、内涵的精神内核作为支持,这才是除了设计以外,对于一个潮牌而言的灵魂,比如Supreme、Stussy、Champion。
而你将在这次旅程中,结合文化+商业模式,去学习正确的潮牌运营思维:
√你会学习现象级潮牌运作规律,掌握潮牌、球鞋的文化价值
√深入Adidas、Puma、Nike等品牌内核及发展规律
√实地拜访北京球鞋文化鼻祖店铺,从潮流界大佬中获得经验
√参与潮牌联名Workshop,跨出做潮牌的第一步
潮牌不止是一种文化,更是一个商业计划。作为Instergram上的网红潮牌Off-White、VLONE……让我们看到了做个人潮牌成功的可能性。
还在想方设法讨好招生官? 不如让他成为你的粉丝吧!
此项目学生人均获得Offer数: 5.58份

特别收获:
-
个性化专业推荐信
-
高质量潮牌联名设计方案
了解更多潮牌项目信息
错过这次,只能再等一年
探秘过程控制原理
斯坦福过程控制与动力学

在所有理工学科里,要说最像魔法的,那还得是化学。
只消把各种反应物混合,加以适当的反应条件,沿着反应方程式,化学原理就能帮你把A变成B,把自然界物质变成为人所用的工业产物。现代社会每日昼夜不停的运转,离不开化学反应、化工合成的控制作用。
在实验室做反应简单,无非是手掌大小的瓶瓶罐罐,来回舞弄。但要撑起现代社会奔忙的步伐,提供人类所需的各种生产生活物资,支撑庞大社会机器运转,这种化学反应还得靠“化学反应釜”,及其背后的过程控制系统来实现。
本项目中,斯坦福大学化学工程系的终身教授就将带你探秘,现代社会化工生产背后的种种原理,包括过程动力学及过程PID控制,化学反应釜的工作原理。
此外,你还将接触高等数学中的精髓部分:线性微分方程和拉普拉斯变换。提前走进高级数学世界,掌握同龄人未曾掌握的绝密知识。让斯坦福终身导师这样的顶配师资,为你走入高阶科研世界铺路。
特别收获:
全球TOP10名校终身教授推荐信
国际期刊专业论文发表
了解更多化学项目信息
错过这次,只能再等一年
给自己选择价值1000亿的未来
哥大转化生物学科研课题
心动指数: 9分
适合方向: 生物、计算机、统计
项目地点: 线上授课
随着不断涌现的移动医疗,信息化和智能化成为生物、医疗事业发展的趋势。
据统计,我国智慧医疗的市场规模将达到1000亿。谁能提前投身智慧医疗领域,谁就有可能站上风口,成为未来的社会宠儿。
疫情可以看出,线上行业注定是风口,如果你作为理工科,想投身科研,最好选择这个价值过千亿的行业作为起点。
没有任何华而不实的头衔,来自哥伦比亚大学的终身教授就是硬实力。
在这次项目中,他就将带你研究最尖端的”生物信息学“,用计算机、统计知识,将基因、用药、疾病等信息一次集合,把欧美当今最新掌握最前沿的科研成果,与你毫无保留地分享。
TOP30名校?科研深造?高薪求职?一次课程足以让你找到答案。
此项目学生人均获得Offer数: 5.52份
特别收获:
-
全球TOP10学校终身教授推荐信
-
国际期刊专业论文发表
了解更多项目内容
让风险成为你的好友
国际经济与对外投资实践研究

心动指数: 9分
适合方向: 经济学
项目地点:北京
2020年开局有点艰难,裁员、疫情……国内经济形势似乎一片荒芜。
然而跳出国内,放眼全球,你会在发现其他地方也有“繁荣的春天”,关键在于,聪明人才懂得,要用国际化的眼光去投资,让风险成为你的机遇。
关键是,你跟上形势了吗?
在全球化进程的今天,经济学背景更是对格局提出了新的要求,以“对外投资”为高度的视野,可以帮助你正确理解国际经济与政策的关系,让你在众多学子中脱颖而出的关键。
在本次旅程中,你将深入了解国际化投资知识:
√美国主权债务可持续性与中国外汇储备管理;
√分析及比较全球财富基金的投资行为和模式;
√“一带一路”、投资风险和境外直接投资;
√学习国际投资风险评估的模型和指标;
你将学会对国际投资发展做出你的预判,从更高的角度去思考对外投资的意义,全方位提高你对投资、外贸、货币三位一体的金融体系思维。
更重要的是,学会解读国际经济与宏观政策,能够构建你的国际化视野与宏观经济思维,无论你从事哪个行业,都将受益一生。
有人看到的是寒冬,有人看到的是机会,你呢?
此项目学生人均获得Offer数: 5.81份

特别收获:
-
权威导师推荐信
-
高含金量学术研究报告
了解更多对外投资项目信息
错过这次,只能再等一年
在数学中找到人生答案
中科院系列-数学建模科研实践

心动指数: 9分
适合方向: 微数学、计算机、工程、物理
项目地点: 中国科学院·数学与系统科学研究院
不仅仅在各行各业,在申校招生官面前,一个拥有出色数学能力的人,相当于:
-
清晰严密的逻辑思维
-
高效解决问题的能力
-
高智商的决策模式
在这次的旅程中,就是你提高数学能力的一个最好机会。
你将会在中科院接受由天才级教授带来规范而系统的数学训练,帮助你培养清晰、逻辑严密的思考模式,极大程度地让你在数学领域获得更大提升。
你将需要学习以下系列知识:
√微积分、矩阵、线性方程
√数值计算,差分和微分建模
√matlab操作,数学建模思路与途径……
除此以外,你将获得冲击中国大学生数学建模大赛的机会,用数学模型,去获得属于你的第一个奖杯,为履历划上精彩的一笔。
中国人的数学能有多好?用你的实力让招生官惊呼“wow”,这就是获得offer的最优解!
此项目学生人均获得Offer数: 4.89份

特别收获:
-
中科院教授推荐信
-
中科院数学建模实践研究项目证书
了解更多数学建模项目信息
错过这次,只能再等一年
未来估值10亿的职业
Python编程与AI计算大数据分析

心动指数: 9分
适合方向: 计算机科学、数据分析、商科、人工智能
项目地点: 北京
所有的互联网公司,想要有一款优秀的产品,必然需要一个能力够强的程序员。
Facebook创始人在成功打造这款产品前,已经写过不少APP并赚了人生第一桶金,而你离下一个估值10亿的APP,只需要给自己一个开始——来中科院学习顶尖的编程知识。
自学成才在互联网急剧发展的时代已经不适用了,让业界大牛带你领略前沿的技术,提前和职业程序员接轨,才是最佳方式。
在10天中,你会进行Python语言学习,极大地提高自身的编程能力,同时学会运用P语言去完成项目进度,通过1:1真实体验程序员作为项目中的一环,所需要承担的责任与担当。
你更会进入全英文的语言环境进行编程学习,体验最地道的美国西海岸硅谷程序员氛围,与国际接轨,用更高的思维去思考编程逻辑,提高你的视野和格局。
无论是结构化思维方式,还是你的代码编程技能,所有作为一名出色的程序员所需要的技能点,都会在这一次进行点亮,而你所需要的,就是全身心地投入和学习。
招生官?也许你最后面对的是顶尖投资人!
此项目学生人均获得Offer数 : 5.58份

特别收获:
-
权威导师推荐信
-
点亮Python语言技能点
了解更多Python项目项目信息
错过这次,只能再等一年
隐藏在DNA中的“上帝”
中科院生物细胞基因探索科研实践

心动指数 : 9分
适合方向: 生物、化学、基因工程、医药
项目地点: 中科院
人类的身上有太多秘密,而破解这个秘密的钥匙就在于——基因。
基因决定了大部分人的性格,如果你能了解基因,小方面看是拿到TOP30 offer的超强优势,直接秒杀其他申请生物专业的学生,往大方面看,你很有可能影响人类的发展进程。
这个项目中,你将参与一系列深度的基因工程实验:
√ 肿瘤细胞及癌细胞观测及培养
√基因测序及天赋基因检测
√小白鼠解剖及研究
√各类科研级实验:电泳、转膜、靶蛋白抗体孵育等
在整个基因实验过程中,你能受到国内最前沿的基因工程体系训练,这是生物专业学生一次性价比极高的探索之旅。
除此以外,你还会拥有一次免费的天赋基因检测,与其去相信上帝的存在,为什么不选择靠自己的勤奋努力,成为自己的“上帝”呢?
没有一个科研人员没有幻想过要成为“造物主”,这也是人类不断发展的动力之一。
来中科院,大胆地开始吧,这不是自我膨胀,这是知识的力量。
此项目学生人均获得O ffer数: 4.77份

特别收获:
-
导师推荐信
-
属于个人的天赋基因检测报告
了解更多基因探索信息
错过这次,只能再等一年
耶鲁教授带你开发未来能源
物理学在能源与工程领域应用项目

心动指数:9分
适合方向:物理
从最初诞生至今,人类已经在这座蔚蓝的星球,生活了四百多万年。
四百多万年间,人类经历了无数风雨,但使我们物种发生革命性变化的,只有几个关键节点,“学会用火”,就是其一。火的加入,使早期人类吃上饿了烤熟的肉,火消灭了肉里的有害微生物,从而使人类物种得以繁殖、演化。
是的,人类命运的改变,总是伴随着能源的变化与发展。可以说,一部人类进化史,就是一部能源发展史。只可惜,如今伴随着化石燃料的过度开采,全球变暖问题日益威胁人类,如何快速寻找并规模化开发全新的未来能源,正是全世界人类的最棘手问题。
在这个项目中,耶鲁大学终身教授,美国物理协会院士就将带你了解当下最前沿的未来能源开发进展,带你认识能源和工程领域中物理学的具体运用,让你走到全球科学实力的头排,近距离了解能源问题。
过去,聪明人才去学物理,现在,聪明的人不仅学习物理,还学习能源。毕竟,动动脚趾也知道,在能源问题日趋严峻的今天,扎根能源领域,都将成为未来社会的稀缺人才。
此项目学生人均获得Offer数:4.58份
特别收获:
全球TOP10学校终身教授推荐信
国际期刊专业论文发表
了解更多物理研究项目
错过这次,只能再等一年
从社交困难症中解脱
哈佛大学心理学课程

心动指 数: 9分
适合方向: 心理学
项目地点: 线上授课
-
明天就要考试了今天还在熬夜玩手机;
-
想和心仪的对象主动打招呼却没有勇气;
-
知道会胖却还是忍不住半夜吃零食……
以上这些事情,是不是你经历过的呢?无论大事小事,所有的一切决定,都来自于你自己。
而要对生活做出改变,第一步就是了解你自己,让自己的心灵轻盈起来。
你需要的不是发朋友圈打卡,不是在自我催眠,而是坚实有力的心理学知识和一个指路人。
喜欢宅在家的人,也许不是“害怕社交”,而是担心不被人喜爱。了解自己很难,100个申校的,也许有99个连自己几点睡都无法决定。
你需要做的,就是让招生官看到——你很清楚自己到底是谁。
此项目学生人均获得Offer数: 4.58份
特别收获:
-
全球TOP10学校终身教授推荐信
-
国际期刊专业论文发表
了解更多心理学研究项目
错过这次,只能再等一年
成为新闻界的“吹哨人”
哥伦比亚大学新闻课程

心动 指数: 9分
适合方向: 新闻学
项目地点: 线上授课
哥伦比亚大学成立于1745年,是美国常春藤联盟院校之一。该校的研究生学院以学术成就闻名于世,同哈佛大学及芝加哥大学一起背公认为美国高等教育的三强。其中以医学、法学新闻学等专业尤为著名。
其中,哥伦比亚大学新闻学院(在2014年USNEWS美国综合大学排名中列第4)颁发的“普利策奖”,是美国新闻界的最高荣誉。
哥大教授将会教会你如何用新闻写作,如何用中立客观的立场报道真相。
从《纽约时报》20年的任职经到写出《写大城市:覆盖纽约》课程,他绝对是名副其实的,不少记者心中的指路明灯。
报名吧,不要等到不能发声的那天,才想起自己什么都没有做。
此项目学生人均获得Offer数: 5.08份
特别收获:
-
全球TOP10学校终身教授推荐信
-
国际期刊专业论文发表
错过这次,只能再等一年
人生海海
劈浪前行
当机会来敲门
请给自己一个了解的机会

更多国内外高端课外活动
